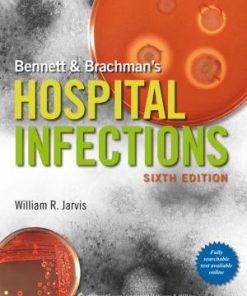
Bennett & Brachman's Hospital Infections 6th Edition

Shop
Showing 4924–4932 of 26071 results
-

Bellwether Media The Muscular System
د.إ46.00 Add to cart Quick View Compare -

Beneficial Microbes for Sustainable Agriculture under Stress Conditions
د.إ1,176.00 Add to cart Quick View Compare -
Sale!

Benzodiazepine-Based Drug Discovery
Original price was: د.إ789.00.د.إ567.00Current price is: د.إ567.00. Add to cart Quick View Compare -
Sale!

Berne & Levy Physiology
Original price was: د.إ764.00.د.إ300.00Current price is: د.إ300.00. Add to cart Quick View Compare